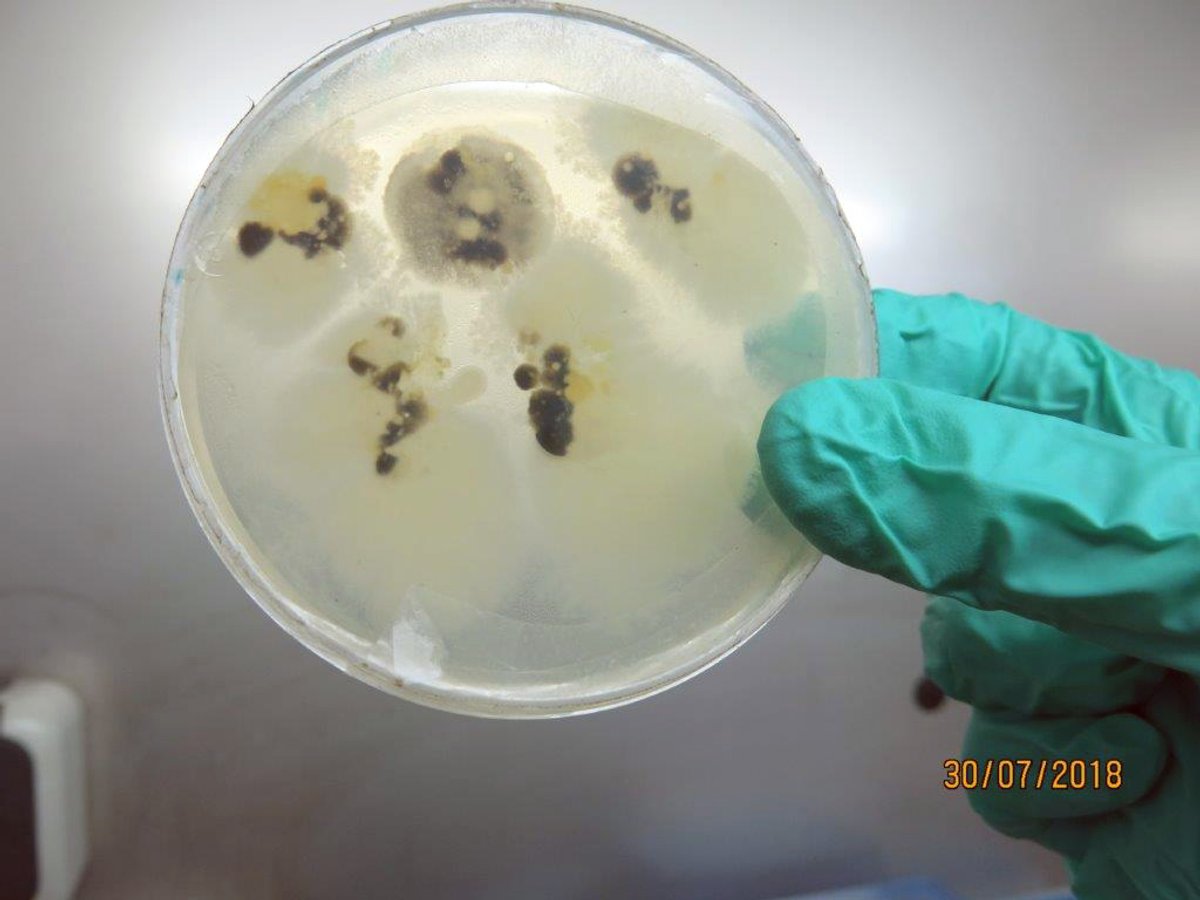

Das Bayerische Landesamt für Gesundheit und Lebensmittelsicherheit in München hat die Labordose untersucht und darin lediglich Spuren von harmlosen Mikroorganismen aufgefunden, die regelmäßig in der Umwelt und auf Lebensmitteln vorkommen. Damit steht fest, dass der Inhalt der Petrischale für Menschen unschädlich war. Angesichts dieses Untersuchungsergebnisses sind keine Anhaltspunkte zur Annahme einer strafbaren Handlung ersichtlich.
Fund löste Großeinsatz der Rettungskräfte aus
Der Fund der Petrischale hatte einen umfangreichen Polizeieinsatz verursacht. Ein Reisender hatte aus dem Gepäcknetz hinter dem Vordersitz eine Zeitung entnehmen wollen und die Petrischale entdeckt. Daraufhin war das Wagenteil mit 51 Reisenden evakuiert worden. Feuerwehrleute waren in Schutzanzügen angerückt und sicherten das Döschen in einer Vakuum-Spezialbox für Gefahrgut. Noch Sonntagabend ging der Fund an das Landesamt für Gesundheit und Lebensmittelsicherheit nach München.